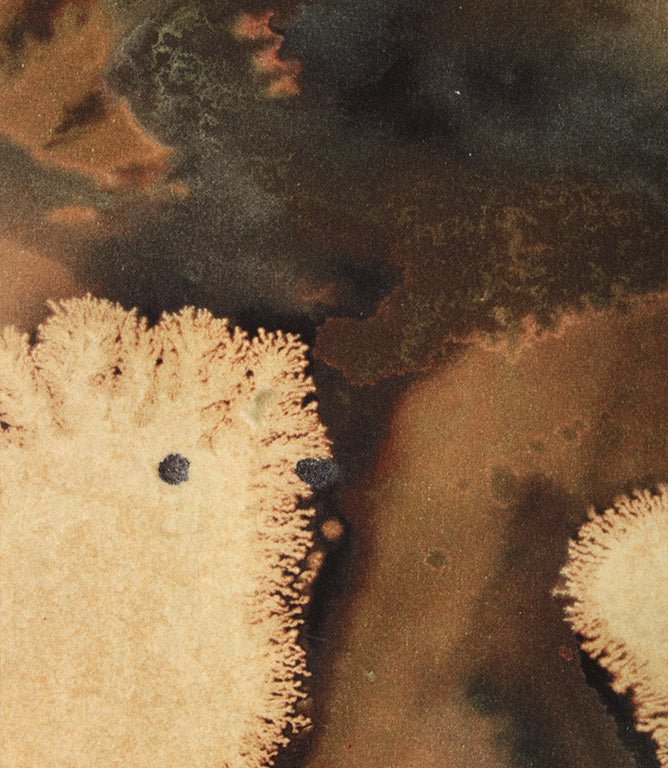
Blaise Fabric / Sand - Just Fabrics

Blaise Fabric / Sand
- 1M
- 2M
- 3M
- 4M
- 5M
- 6M



More Curtain Headings






Choose Curtain Lining
Single Layer Lining
Standard Lining
Using a lining helps your curtains and blinds to hang well and protect them from sunlight.
Thermal Lining
This lining will add extra insulation to your curtains helping to keep you warm and lower your energy bills.
Blackout Lining
This lining is the ideal choice for a bedroom as it cuts out the light. The colour of this lining is cream. Also helps for insulation as it has thermal properties.

Double Layer Lining
Lined and interlined
Having your roman blinds lined and interlined gives them a fuller and more luxurious look. It also adds another layer of insulation to your roman blinds, increasing their thermal properties.
Thermal and interlined
All the benefits of interlining plus extra insulation, very cosy. These curtains can be very heavy so you need to ensure that your track or pole is suitable for the weight.
Blackout and interlined
All the benefits of an interlined curtain plus the benefits of a blackout lining – an ideal choice for a warm, cosy and dark bedroom!

No Lining



Add Cushions
- 38cm
- 43cm
- 48cm
- 53cm
- 58cm
- 63cm






Add Tiebacks



We custom-make your blinds to the exact width you specify.
Roman blinds: For a recess fit, deduct at least 0.5cm from the recess width to ensure smooth operation (except for blackout Roman blinds, which may require a tighter fit).
Roller blinds: Please note there is approximately a 1.5cm gap on each side between the edge of the fabric and the outside edge of the brackets.
Need help? Check our measuring guides for


Blind Lining
Single Layer Lining

Double Layer Lining






Add Cushions
- 38cm
- 43cm
- 48cm
- 53cm
- 58cm
- 63cm



All cushions come with a feather inner
- 38cm
- 43cm
- 48cm
- 53cm
- 58cm
- 63cm
Piping will be made in the same fabric as your cushion



Pay in 3 interest-free payments
Available for purchases of £20 to £3,000. No sign-up fees or late fees.
- Choose PayPal at checkout to pay later with Pay in 3.
- Complete your purchase with the first payment today.
- Remaining payments are taken automatically.
Fast dispatch on all sewing machines
Fast dispatch on all sewing machines
Sewing machines are usually dispatched within 2 working days, however during busier periods can take up to 4 working days, dependant on stock availability.
SAVE 15% OFF all Linings when you buy 10m or more of fabric
Save 15% off all Linings when you buy 10m or more of fabric
Add 10m or more of fabric to your basket and get 15% off all linings, discount will be applied directly at checkout.




Waiting for content...
Contact Our Team of Experts
Whether you have a small question, know your sizes and want a quote or would like to speak and schedule an appointment with our team, complete the form below.
Why Shop with Just Fabrics
-
Simple Order Process
You can create a bespoke order online within minutes.
-
Great Customer Service
We pride ourselves on the service we provide.
-
Contract Service
We work with you to ensure your needs are met.
-
30 Years' Experience
Just Fabrics has been a leading supplier of fabrics in the UK for over 30 years.
-
5 Year Guarantee
Highly skilled workroom teams.

Pay in 3 interest-free payments
on purchases from £30-£2,000

All our curtains & blinds are
Expertly hand-finished in the UK
Lead time 4-6 weeks
Inspired by the patterns in space, this quirky 100% BCI cotton fabric will instantly add statement design in interiors. With warming colours, Blaise is a curtain and blind fabric and can also be used for upholstery projects such as making into cushions and recovering a footstool.
Delivery & Returns Information
Fast dispatch on all in stock orders.
For more details and timescales for made to measure products please click here.
Here at Just Fabrics we take great effort to ensure the products we sell are represented as accurately as possible on screen through multiple images and text. However, colours on screens can vary, so on certain items we offer a sampling service which we advise all customers to use prior to placing an order.
Velvets, PVC, FR, double width and heavier upholstery fabrics are sent rolled and therefore must be sent via courier, incurring the higher delivery charge.
Fabrics & Made to Measure are cut to your bespoke order requirements and are non-returnable unless faulty.
For more details on Returns & Refunds click here.
Recently Viewed Products
JF Creations
We love seeing how you use our fabrics to make your house a home. Share your photo here for the chance to win a £10 voucher
Why Choose us?

Curtains & Blinds hand-finished in the Cotswolds
Precision craftsmanship,
made with care

Family-run for
over 30 years
Heritage, quality,
and fair prices

Personal, knowledgeable
& friendly service
Expert advice with
trusted reviews
-

Curtains & Blinds hand-finished in the Cotswolds
Precision craftsmanship,
made with care -

Family-run for
over 30 yearsHeritage, quality,
and fair prices -

Personal, knowledgeable
& friendly serviceExpert advice with
trusted reviews